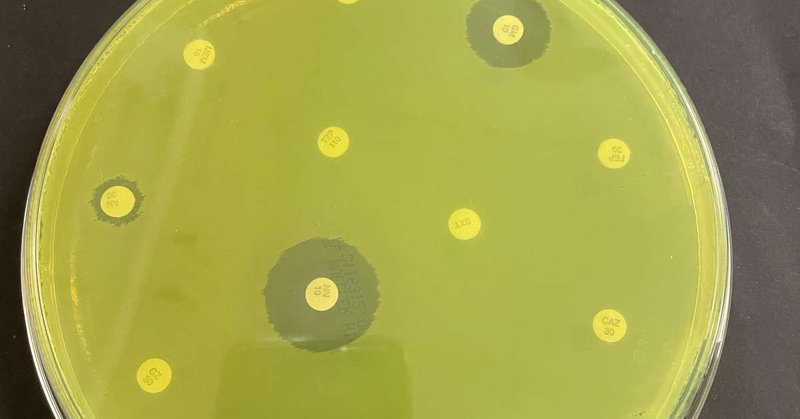
Tweet card summary image

UCLA Updates
@UCLAUpdates
Followers
28K
Following
3K
Media
4K
Statuses
11K
Official channel for @UCLA news, stories, research, and updates. #ResearchPowersProgress (Also on Bluesky!)
Los Angeles
Joined May 2008
UCLA law professor and voting rights expert Rick Hasen weighs in on the congressional redistricting measure.
newsroom.ucla.edu
UCLA law professor and voting rights expert Rick Hasen weighs in on the congressional redistricting measure.
2
2
8
#NativeAmericanHeritageMonth invites us to learn from and celebrate the Indigenous peoples whose contributions, culture and resilience continue to shape @UCLA and our world. Explore stories across campus and our community:
newsroom.ucla.edu
A curated selection of stories from across the UCLA campus spotlighting Native American voices, histories and research.
0
1
10
Professor Cecilia Rios-Aguilar co-authored this piece on how the federal government shutdown adds more complications for those who need college financial aid:
edsource.org
The federal government shutdown has caused California students and families to face a more complicated financial aid process, delaying access to federal awards and requiring additional time to...
0
0
2
Latest Teens & Screens report shows that yes, they still watch TV and movies and want more content centered on mix-gendered friendships not romance
newsroom.ucla.edu
Center for Scholars & Storytellers at UCLA’s annual study finds adolescents prefer relatable on-screen content.
0
0
0
In celebration & recognition of the 56th anniversary of the Internet (October 29, 1969), I asked the actual creator of the Internet, Leonard Kleinrock of UCLA, what he thinks of the Internet today. This is a VERY insightful & eye-opening response.
4
35
144
UCLA professor Terence Tao and postdoctoral scholar Vidya Saravanapandian on America's changing science infrastructure, which have left many questioning its future - via @NewsHour #ResearchPowersProgress
https://t.co/JKNwBe2CdI
pbs.org
A poll from the journal Nature found that 75% of researchers in the U.S. are considering leaving the country. That includes a man who’s been dubbed the "Mozart of Math." Stephanie Sy examines what’s...
0
2
3
Professor Rick Hasen dives into the nitty-gritty to explain what Proposition 50 does and what’s at stake during this California statewide special election: https://t.co/Amn3toVouj
0
1
2
🤔 What exactly is a "Self-Custodial" wallet? Simply put: It’s a digital wallet where YOU hold the keys and total control of your assets. Unlike traditional banks or centralized exchanges: - No permission needed to withdraw - No account freezes - Access to dApps & DeFi
6
5
23
What percentage of Californians had difficulties paying for their medical bills? Could not afford enough food? Delayed care? These topics (and more!) will be covered at the California Health Interview Survey annual data release TOMORROW: https://t.co/yxI1AOx82Z.
0
1
5
"With today’s recognition, UC faculty who have won a remarkable 74 Nobel Prizes. These awards are tangible evidence of the work happening across the University of California every day to expand knowledge, test the boundaries of science, and conduct research that improves our
universityofcalifornia.edu
UC President James B. Milliken statement following the announcement of the Nobel Prize in physics, awarded to 3 UC professors: John Clarke of UC Berkeley and Michel H. Devoret and John M. Martinis of...
2
13
47
Congratulations to former UCLA professor Omar Yaghi on winning the Nobel Prize in chemistry for his pioneering work in the development of metal-organic frameworks. Read more: https://t.co/pEij6tx65J
2
14
43
BREAKING NEWS The 2025 #NobelPrize in Physiology or Medicine has been awarded to Mary E. Brunkow, Fred Ramsdell and Shimon Sakaguchi “for their discoveries concerning peripheral immune tolerance.”
466
12K
29K
We're very proud of UCLA alumnus Fred Ramsdell for receiving The @NobelPrize in Physiology or Medicine — our 17th Nobel Prize for an alum or faculty member, and the third prize in five years for a Bruin. https://t.co/4zhy7ysFsk
#NobelPrize
newsroom.ucla.edu
Ramsdell, who earned his doctorate in microbiology and immunology at UCLA in 1987, was one of three researchers honored for their work on the human immune system.
3
27
88
Campus computer labs have come a long way. At @UCLA, students now have access to a state-of-the-art Bruins Esports & Gaming Lounge inside Ackerman Union. @richontech reports: https://t.co/3C4LvefkPm
ktla.com
Campus computer labs have come a long way. At UCLA, students now have access to a state-of-the-art Bruins Esports & Gaming Lounge inside Ackerman Union. “It’s something that our students and ot…
2
2
13
UCLA Anderson Forecast: Risk of rising layoffs leading to a recession is a tangible possibility
newsroom.ucla.edu
Read more from the Forecast's outlook for the national and California economies — where they are now and when they will recover.
5
1
10
When a half-dozen local patients were infected with a virulent strain of a hospital acquired bacterium that is rarely found in the US, a @UCLA team used sophisticated techniques to track it to an unexpected source and defeat it. Read more:
uclahealth.org
4
7
13
In a KCRW interview, a patient and scientists discuss the uncertain future of biomedical discoveries.
newsroom.ucla.edu
In a KCRW interview, a patient and scientists discuss the uncertain future of medical research.
3
4
8
Prof. Gay M. Crooks studies stem cell transplantation for immune deficiencies. Over 6 million people worldwide have been immunodeficient since birth, and her research offers new ways to restore these patients’ immune systems. #ResearchPowersProgress: https://t.co/csX403THnT
0
5
26
.@UCLA prof. Megan Sweeney studies how economics, race & social dynamics shape family life. Her research also trains future demographers who inform policy & forecast economic trends, helping society plan for population shifts. #ResearchPowersProgress
https://t.co/ES6H3JwP9j
0
3
17
The @UofCalifornia is one community, educating the next generation, driving discovery and delivering life-saving care. Now we need your voice. Share your UC story and help us #StandUpForUC:
universityofcalifornia.quorum.us
Add your voice. Protect our future.
0
1
5
This summer, Jenny Gao is putting her Luskin training into action at @aboutKP on national initiatives that make patient care more personalized. #UCLALuskin #PublicPolicy
luskin.ucla.edu
From classroom to care strategy: A Luskin Public Policy student’s summer at Kaiser Permanente shaping patient-centered health policy.
0
1
3